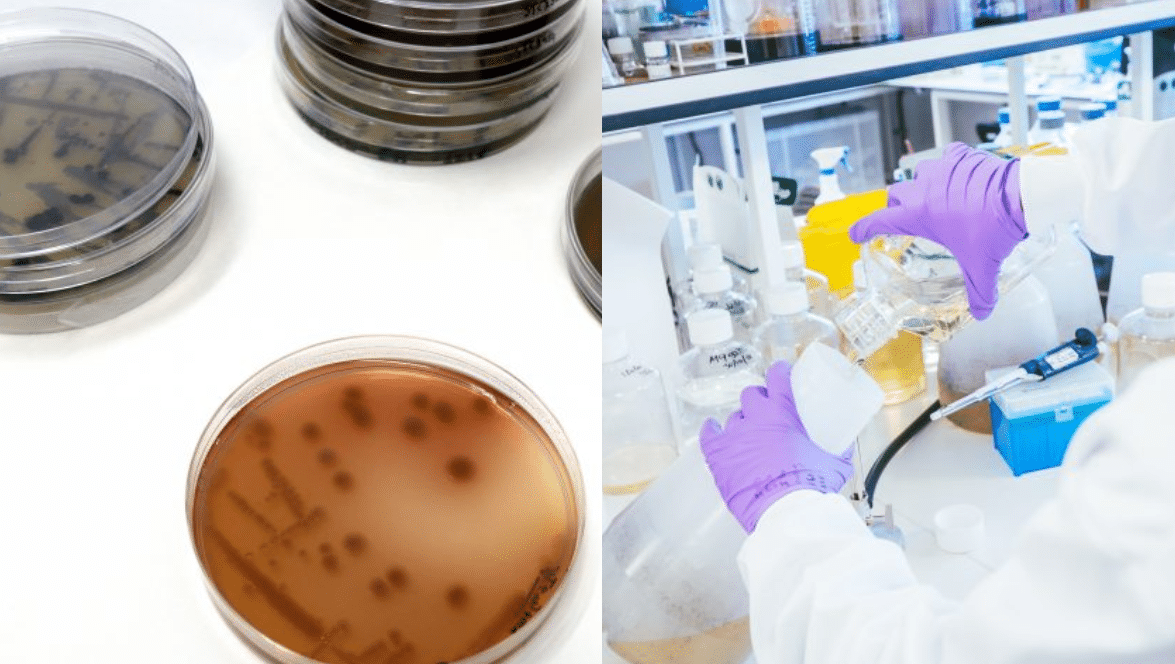
colorifix 02

Colorifix บริษัทด้านไบโอเทคในอังกฤษอาจกำลังปฏิวัติวงการแฟชั่นอีกครั้ง กับการนำจุลินทรีย์มาสร้างสีสันให้ผ้าแทนสีย้อมในปัจจุบัน ซึ่งคาดว่าจะช่วยลดมลพิษให้กับโลก และสามารถประหยัดน้ำที่ต้องใช้ในการย้อมสีได้อย่างมาก
สิ่งที่ Colorifix ระบุไว้ในเว็บไซต์ก็คือ สิ่งมีชีวิตตามธรรมชาติบางส่วนสามารถสร้างสีขึ้นเองได้ (ทั้งสัตว์ พืช แมลง หรือจุลินทรีย์) และด้วยการจัดลำดับดีเอ็นเอออนไลน์ มนุษย์สามารถระบุยีนที่แน่นอนซึ่งนำไปสู่การผลิตเม็ดสีนั้น ๆ ได้ จากนั้นก็แปลรหัสดีเอ็นเอลงในจุลินทรีย์ และจุลินทรีย์ที่ได้รับการออกแบบทางวิศวกรรมจะเป็นผู้ผลิตเม็ดสีออกมา โดยมนุษย์ทำหน้าที่แค่ให้อาหารอย่างน้ำ น้ำตาล ยีสต์ ฯลฯ กับจุลินทรีย์ เพื่อให้มันเติบโต ซึ่ง Orr Yarkoni ผู้ก่อตั้ง Colorifix ระบุว่า การที่จุลินทรีย์แบ่งตัวทุก ๆ 20 นาที ทำให้ภายใน 1 – 2 วัน มันก็สามารถสร้างสีย้อมในปริมาณที่มากพอจะใช้ในการย้อมผ้าในเชิงพาณิชย์ได้แล้ว และมีสารเคมีน้อยกว่าการย้อมผ้าโดยใช้สีสังเคราะห์อย่างมากด้วย
สีจากจุลินทรีย์ประหยัดน้ำ – ไฟ ได้มากกว่า
นอกจากนั้น ทาง Colorifix ยังแสดงให้เห็นว่า กระบวนการย้อมสีของพวกเขาใช้น้ำน้อยกว่าการย้อมสีแบบปัจจุบัน 81% และใช้ความร้อนจากก๊าซธรรมชาติน้อยกว่า 41% เหตุที่เป็นเช่นนั้นเพราะจุลินทรีย์ต้องการอุณหภูมิแค่ 37 องศาเซลเซียสในการเติบโต แต่ถ้าเป็นการย้อมผ้าแบบปกติต้องใช้ความร้อนสูงถึง 80 – 130 องศาเซลเซียสเลยนั่นเอง
ทั้งนี้ การใช้สีย้อมผ้าในอุตสาหกรรมแฟชั่นปัจจุบันได้ก่อมลพิษให้กับโลกมากมาย เห็นได้จากรายงานของหลายองค์กร รวมถึง the Ellen MacArthur Foundation ที่ระบุว่า การย้อมสีในอุตสาหกรรมสิ่งทอ เป็นตัวก่อมลพิษทางน้ำมากถึง 1 ใน 5 ของปัญหามลพิษทางน้ำที่โลกเผชิญเลยทีเดียว ส่วนสาเหตุที่วงการแฟชั่นต้องกลายเป็นผู้ก่อมลพิษให้กับสิ่งแวดล้อมสูงมากนั้น มาจากการเลือกใช้สีสังเคราะห์ในการย้อมผ้าแทนสีจากธรรมชาติ เพราะให้ผลลัพธ์ที่แน่นอนกว่า การพัฒนาสีจากจุลินทรีย์จึงอาจเป็นทางเลือกใหม่ของวงการแฟชั่นในอนาคต
H&M – Pangaia เริ่มแล้ว ใช้สีจากจุลินทรีย์
Colorifix ยังเผยด้วยว่า พวกเขาได้รับการติดต่อจากแบรนด์ที่ใส่ใจด้านสิ่งแวดล้อมในการใช้สีของพวกเขาไปผลิตสินค้าแฟชั่น เช่น H&M, Pangaia ฯลฯ (ปัจจุบันมีวางขายเป็นเสื้อแบบมีฮู้ดในราคาประมาณ 180 เหรียญสหรัฐฯ)
ส่วนความท้าทายที่พวกเขาเผชิญในตอนนี้คือเรื่องของกำลังการผลิต เนื่องจากแบรนด์ต่าง ๆ ที่ติดต่อเข้ามานั้น มีความต้องการที่หลากหลาย และสีที่ต้องการก็มีความแตกต่างกัน
อย่างไรก็ดี การมีสีจากจุลินทรีย์เป็นอีกหนึ่งทางเลือกของวงการแฟชั่น อาจไม่มีผลกระทบต่อรายได้ของผู้ผลิตสีย้อมผ้าแบบดั้งเดิมมากนัก เพราะ Barclays Bank คาดการณ์ว่า อุตสาหกรรมดังกล่าวยังมีแนวโน้มที่จะเติบโตต่อไป และมีรายได้ทะลุ 16,100 ล้านเหรียญสหรัฐฯ (ประมาณ 5.55 แสนล้านบาท) ภายในปี 2030 ด้วย